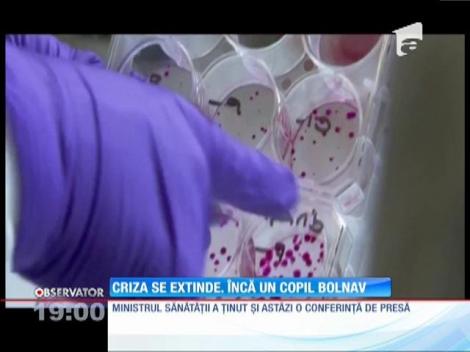
Copil transferat de urgenţă din Bacău, la Iaşi. Are aceleaşi simptome ca pruncii din Argeş

Articole despre transferat

Harvey Weinstein va fi transferat la închisoarea de stat din New York
Harvey Weinstein va fi transferat la închisoarea de stat din New York, după două zile de când a ajuns la cea din Rikers, potrivit Variety.
Miercuri, 18.03.2020, 17:58
Martin Braithwaite, transferat oficial de la Leganes la FC Barcelona
FC Barcelona a anunţat că l-a transferat pe jucătorul Martin Braithwaite, în vârstă de 28 de ani, de la Leganes, catalanii achitând clauza de reziliere a contractului danezului, în valoare de 18 milioane de euro.
Joi, 20.02.2020, 14:09
Miron, oficial la FCSB
FCSB a anunţat, miercuri, transferul fundaşul Andrei George Miron de la Fotbal Club Botoşani.
Miercuri, 19.02.2020, 16:22
FC Argeş l-a transferat pe fundaşul Mihai Leca
FC Argeş a perfectat miercuri cel de-al cincilea transfer din această iarnă, după ce a ajuns la o înţelegere până la finalul acestui sezon, cu drept de prelungire, cu fundaşul Mihai Daniel Leca.
Miercuri, 19.02.2020, 12:44
Hakim Ziyech, transferat de Ajax Amsterdam la Chelsea la 1 iulie, în schimbul a 40 de milioane de euro
Clubul Ajax Amsterdam a anunţat, joi, că a ajuns la un acord cu Chelsea pentru transferul jucătorului Hakim Ziyech la gruparea londoneză în data de 1 iulie.
Joi, 13.02.2020, 15:11
Laurenţiu Corbu, transferat de Dinamo la Chindia Târgovişte
Dinamo Bucureşti şi Chindia Târgovişte au ajuns la un acord pentru transferul definitiv al fundaşului Laurenţiu Corbu la clubul dâmboviţean, anunţă clubul dinamovist.
Luni, 10.02.2020, 16:28
Barcelona a transferat un atacant de 20 de ani de la Braga pentru 31 de milioane de euro şi i-a fixat o clauză de reziliere de 500 de milioane de euro
FC Barcelona l-a transferat pe atacantul Francisco Trincao de la echipa Sporting Braga, a anunţat, vineri, clubul portughez.
Vineri, 31.01.2020, 14:15
Christian Eriksen, transferat de la Tottenham la Inter Milano
Mijlocaşul danez Christian Eriksen a fost transferat de la Tottenham la Inter Milano, pentru suma de 20 de milioane de euro, informează BBC.
Marti, 28.01.2020, 15:35
FC Sevilla l-a transferat pe En-Nesyri de la Leganes cu 20 de milioane de euro
FC Sevilla a anunţat, joi, că l-a achiziţionat pe atacantul Youssef En-Nesyri de la Leganes, suma de transfer fiind, potrivit presei, 20 de milioane de euro.
Joi, 16.01.2020, 17:40
Ministerul Justiţiei anunţă că un cetăţean român aflat în închisoare în China va fi transferat în România
Ministerul Justiţiei anunţă că românul Marius Balo, care execută o pedeapsă cu închisoarea în China, va fi transferat în România, autorităţile chineze aprobând acest transfer.
Joi, 09.01.2020, 15:02
Caz de gripă în București! O fetiță de un an şi jumătate a fost adusă de urgență în Capitală
O fetiță în vârstă de un an și jumătate, diagnosticat la testul rapid cu gripă de tip A, a fost transferată, marți dimineață, la Spitalul Matei Balş din Capitală, de la Spitalul Judeţean Buzău.
Marti, 07.01.2020, 09:52
Becali l-a găsit vinovat pe Mihai Stoica şi pentru faptul că nu l-a transferat pe Mitriţă; Despre posibilitatea revenirii lui Stoica la FCSB: Nu am nevoie de el, dar are uşa deschisă
Patronul FCSB, Gigi Becali, l-a acuzat pe Mihai Stoica şi pentru faptul că a ratat transferul lui Alexandru Mitriţă. Becali a precizat că nu are nevoie la club de fostul director sportiv al FCSB, dar dacă acesta cere o slujbă, i-o dă, pentru că este prietenul său.
Vineri, 18.10.2019, 12:50
Gheorghe Dincă, transferat la Spitalul Penitenciar Jilava pentru expertiza psihiatrică
Gheorghe Dincă, bărbatul inculpat în cazul crimelor din Caracal, a fost transferat, marţi, la Spitalul Penitenciar Jilava pentru efectuarea expertizei psihiatrice. Data la care va fi realizată procedura nu a fost încă stabilită.
Marti, 01.10.2019, 14:17
Mario Iorgulescu, transferat într-o clinică din Italia. Poliţiştii şi procurorii nu au fost anunţaţi de mutare
Mario Iorgulescu a fost mutat, astăzi, la o clinică de specialitate din Italia. Transferul a fost făcut la cererea familiei, contrar recomandărilor făcute de medicii Spitalului Elias din Capitală, acolo unde Iorgulescu a fost internat în...
Luni, 23.09.2019, 19:12
DIICOT: Gheorghe Dincă a fost transferat în Centrul de Reţinere şi Arest Preventiv Bucureşti, pentru a fi reaudiat, pentru o analiză comportamentală şi pentru examinarea psihiatrică
DIICOT a anunţat, luni, că Gheorghe Dincă a fost transferat în Centrul de Reţinere şi Arest Preventiv Bucureşti, pentru a fi reaudiat, pentru o analiză comportamentală şi pentru examinarea psihiatrică.
Luni, 02.09.2019, 16:23
Alexandru Măţel, transferat de la FC Hermannstadt la CSU Craiova
Fundaşul Alexandru Măţel a semnat cu Universitatea Craiova un contract valabil pe un an, cu opţiune de prelungire pe încă doi ani.
Luni, 02.09.2019, 14:16
Cristiano Ronaldo: Astăzi orice jucător poate fi transferat pentru 100 de milioane de euro, chiar dacă nu a făcut nimic deosebit
Atacantul echipei Juventus Torino, Cristiano Ronaldo, a vorbit despre sumele mari plătite pentru jucători, într-un interviu acordat postului portughez TVI.
Miercuri, 21.08.2019, 15:00Atacantul Virgil Postolachi a fost transferat de la PSG la Lille pe gratis
Jucătorul de 19 ani, care are şi cetăţenie franceză şi română, a semnat un contract pentru patru ani. Virgil Postolachi a fost transferat gratis, dar PSG va încasa o cotă dintr-o posibilă revânzare a jucătorului.
Joi, 18.07.2019, 12:19
Fundaşul Matthijs de Ligt a fost transferat oficial de la Ajax la Juventus
Fundaşul Matthijs de Ligt a fost transferat de la Ajax Amsterdam la Juventus Torino, a anunţat, joi, campioana Italiei. Jucătorul în vârstă de 19 ani a efectuat, miercuri, vizita medicală, apoi a semnat un contract pe cinci ani cu Juve.
Joi, 18.07.2019, 10:17
Cristian Borcea, în atenția medicilor! A fost transferat într-o rezervă a Penitenciarului Spital Rahova
Cristian Borcea a fost transferat din celula Penitenciarului Rahova într-o rezervă a Penitenciarului Spital Rahova și a cerut să i se facă investigații medicale.
Miercuri, 20.02.2019, 22:30
Copil transferat de urgenţă din Bacău, la Iaşi. Are aceleaşi simptome ca pruncii din Argeş
Cazul bebeluşilor atacaţi de bacteria ucigaşă riscă să ia proporţii naţionale. Un alt copil, suspect de sindrom hemolitic-uremic, a fost transferat de urgenţă din Bacău, la Iaşi. Avea aceleaşi simptome, ca pruncii din Argeş, la debutul...
Sambata, 20.02.2016, 19:08
10 pacienți răniţi în Colectiv, transferați în Norvegia și Marea Britanie
Medicii au făcut un nou pod aerian pentru viaţă. Zece răniţi din Colectiv au plecat azi noapte din ţară la bordul unei aeronave NATO. Unul în Norvegia, ceilalţi în Marea Britanie. Nouă medici şi opt asistenţi le-au fost alături.
Luni, 09.11.2015, 07:16
Update / Gabriel Cotabiţă a fost transferat la Spitalul Elias din Capitală
Gabriel Cotabiţă este un supravieţuitor! După aproape 40 de zile de îngrijire la terapie intensivă, artistul a fost externat din spitalul de urgenţă Floreasca. Lupta însă nu s-a terminat.
Marti, 16.06.2015, 19:13
Gabriel Cotabiţă a fost transferat la Spitalul Elias din Capitală
Gabriel Cotabiţă a fost transferat în această dimineaţă la Spitalul Elias din Capitală. Acolo, artistul va continua procesul de recuperare. Cotabiţă a stat mai bine de o lună internat la Floreasca.
Marti, 16.06.2015, 13:09
Agresorul din Craiova, transferat la Penitenciarul Jilava
Tânărul fugit de două ori din spitalul de psihiatrie din Craiova, care a atacat oameni la întâmplare, a fost transferat la Penitenciarul Jilava. Asta după ce a încercat să-i atace şi pe medicii care îi tratau rănile. Poliţiştii au fost...
Vineri, 29.08.2014, 16:08
Steliştii se mândrec că au transferat un jucător care a jucat în Ligue 1
Meme se dă mare! Steaua transferă din Ligue 1! La echipa "neamţului" Reghe, Keşeru are umlaut pe numele scris pe tricou.
Duminica, 12.01.2014, 09:09
Steaua l-a transferat pe Târnovan
Steaua şi-a luat atacant de Viitor. L-a transferat definitiv pe puştiul Târnovan de la Academia lui Hagi. Steliştii trag şi de Keşeru din Franţa. Fostul dinamovist Zicu ar putea fi marea surpriză pentru 2014. Zicu este prieten cu MM şi ar...
Marti, 31.12.2013, 07:54
Liderul trupei Suie Paparude, transferat la Spitalul de Urgenta din Timisoara
Mihai Capineanu, liderul trupei Suie Paparude, este in continuare in stare grava. In urma cu putin timp, cantaretul a fost transferat la Spitalul de Urgenta din Timisoara. Medicii se tem ca infarctul suferit zilele trecute i-a afectat creierul.
Luni, 21.10.2013, 16:18
Gigi Becali asteapta sa fie transferat
Gigi Becali se pregateste sa bata la poarta altui penitenciar. La Poarta Alba, mai exact. Sefii de la Jilava i-au aprobat transferul. Patronul stelei mai are de trecut un hop inainte sa ajunga in inchisoarea de la malul marii.
Luni, 02.09.2013, 13:08
Gicu Grozav, ca si transferat la Terek Groznai
Gicu Grozav pleaca de la Petrolul. Mijlocasul de 22 de ani merge in Rusia pentru 2 milioane si jumatate de euro. Grozav va juca la Terek Groznai in Premier League sa se bata cu Dan Petrescu si Dorinel Munteanu, in direct la GSPTV.
Joi, 29.08.2013, 07:58
Șeful Inspectoratului Școlar București și-a transferat fiica la un alt liceu, înainte de Bac
Șeful Inspectoratului Școlar al Municipiului București, Constantin Trăistaru și-a transferat fii ca înainte de bacalaureat de la Școala Centrală la Colegiul Național Gheorghe Lazăr.
Marti, 09.07.2013, 09:07
Update / Cascadorul Sobi Cseh a fost transferat la spital
Rugaciunile noastre se indreapta in aceste clipe catre Szobi Cseh. Fostul Cascador trece prin momente grele. In ultimele zile, starea sa de sanatate s-a agravat din cauza unei infectii.
Vineri, 21.06.2013, 16:17
Cascadorul Sobi Cseh a fost transferat la spital
Cascadorul Sobi Cseh a fost transferat la spitalul de boli infectioase Victor Babes.Se pare ca acesta avea febra foarte mare provocata cel mai probabil de o infectie.
Vineri, 21.06.2013, 13:38
UPDATE / Gigi Becali a fost transferat de la Penitenciarul Rahova la cel din Jilava
In mare taina, la adapostul intunericului, Gigi Becali a schimbat domiciliul noaptea trecuta. In viata detinutului B0177, a inceput episodul Jilava, lung de trei ani.
Marti, 11.06.2013, 19:14
Gigi Becali a fost transferat de la Penitenciarul Rahova la cel din Jilava
Gigi Becali a fost transferat, in aceasta dimineata, de la penitenciarul Rahova la cel din Jilava.Omul de afaceri a incheiat duminica perioada de carantina de 21 de zile
Marti, 11.06.2013, 13:34
Gigi Becali, transferat la Penitenciarul Rahova
Gigi Becali a fost transferat din arestul Politiei Capitalei la Penitenciarul Rahova.
Marti, 21.05.2013, 01:03
Afaceriștii români au transferat anul trecut peste 12 miliarde de euro în Cipru
Peste 5.800 de firme românești au ca acționari oameni de afaceri din Cipru. Multe dintre aceste firme și-au mutat în ultimii ani afacerile în insule pentru că fiscalitatea era redusă și nici nu trebui să justifice proveniența banilor.
Marti, 09.04.2013, 10:50
S-a transferat in Asia, dar a cucerit Europa!
S-a transferat in Asia dar a cucerit Europa! Un jurnalist britanic, specializat pe fotbalul est-european, povesteste cum a ajuns Mirel Radoi, unul dintre cei mai influenti fotbalisti din Romania, de dupa Revolutie.
Sambata, 05.01.2013, 09:12
Manchester United l-a luat pe Bolt
Manchester United a transferat cel mai rapid om de pe planeta. Usain Bolt va juca alaturi de Rooney si Van Persie. Chiar Sir Alex Ferguson a anutat transferul. La United, Bolt va juca doar un meci. Dar unul de stele. Impotriva Realului. Partida e una...
Miercuri, 05.09.2012, 20:23
Adrian Nastase a fost mutat pe 17 iulie la Penitenciarul Spital Jilava din motive medicale
Adrian Nastase a fost transferat de la Penitenciarul Spital Rahova la Penitenciarul Spital Jilava, din cauza afectiunilor medicale cronice de care sufera, fiind cazat in Sectia Boli Interne, anunta Mediafax.
Luni, 23.07.2012, 11:37
Oficial: Weldon s-a transferat de la CFR Cluj la echipa chineza Changchun Yatai
Atacantul brazilian Weldon s-a transferat la echipa chineza Changchun Yatai, anunta site-ul oficial al clubului ardelean. Sud-americanul, care a inscris sapte goluri pentru CFR Cluj in prima parte a campionatului, a fost achizionat pentru un milion de euro si va primi un salariu de 800.000 de euro.
Joi, 23.02.2012, 00:00
Oficial: Alexis Sanchez, transferat la FC Barcelona
Alexis Sanchez este, incepand de joi seara, noul jucator al Barcelonei, catalanii ajungand la o intelegere cu Udinese, informeaza site-ul oficial al catalanilor. In schimbul a 26 de milioane de euro, jucatorul din Chile va imbraca tricoul campioanei Europei.
Vineri, 22.07.2011, 00:00
Rapid l-a transferat pe bulgarul Pavel Vidanov
Marius Sumudica a reusit sa-si intareasca apararea cu o saptamina inainte de startul campionatului. Dupa peste 7 ore de negocieri, in care de mai multe ori afacerea parea ca si picata, Rapid l-a transferat vineri seara pe bulgarul Pavel Vidanov, informeaza Gsp.ro
Sambata, 19.02.2011, 00:00
Burdujan a ales Steaua fara conditii
"A acceptat fara sa negocieze", spune Meme Stoica despre Burdujan, proaspat transferat in Ghencea. Fostul rapidist mai are un atuu: e stangaci, la propriu. Sefii Stelei sunt convinsi ca galeria, nu ii va face probleme lui Burdujan.
Joi, 10.02.2011, 20:05
FC Timisoara l-a transferat pe Sorin Ghionea
FC Timisoara a dat lovitura: l-a transferat pe Sorin Ghionea. Fostul capitan al Stelei a semnat cu echipa antrenata de Dusan Uhrin din postura de jucator liber de contract, dupa ce si-a reziliat contractul cu formatia rusa FC Rostov.
Miercuri, 09.02.2011, 00:00
Bogdan Stancu a fost transferat la Galatasaray Istanbul
Cluburile Steaua si Galatasaray au ajuns la un acord final privind transferul lui Bogdan Stancu. Suma de transfer este de 5,6 milioane de euro, jucatorul urmand sa primeasca un salariu total de 7 milioane de euro pentru contractul pe trei ani si jumatate, informeaza cotidianul turc Fanatik.
Joi, 20.01.2011, 00:00
Culio, transferat la Galatasaray
Mijlocasul argentinian Culio a semnat pe trei ani si jumatate cu gruparea Galatasaray Istalnbul, la care antrenor este Gica Hagi. CFR va incasa 1,5 milioane de euro in acest moment, plus inca 500.000 de euro la vara.
Joi, 06.01.2011, 00:00
Steaua II, desfiintata/ Toti jucatorii vor semna cu Unirea Urziceni
Conducerea clubului Steaua Bucuresti a hotarat sa renunte la echipa secunda, urmand ca toata echipa sa se mute la Urziceni, unde vor alcatui noua echipa a Unirii. Singurii jucatori care nu vor semna cu Urziceni sunt Robinson Zapata si Eugen Baciu, care vor reveni la prima echipa.
Miercuri, 01.09.2010, 00:00
Oficial: Zlatan Ibrahimovic a fost transferat la AC Milan
Dupa mai multe zile de negocieri, suedezul Zlatan Ibrahimovic a fost transferat de la FC Barcelona la AC Milan. Atacantul scandinav, in varsta de 28 de ani, va juca la formatia italiana sub forma de imprumut in acest sezon.
Sambata, 28.08.2010, 00:00
Steaua a transferat sase jucatori de la Unirea Urziceni: Bilasco, Galamaz, Apostol, Ricardo, Onofras si Marinescu
Capitanul George Galamaz si Marius Bilasco nu vor veni singuri la Steaua. Finantatorul clubului din Ghencea a anuntat sambata ca alti patru jucatori ai Unirii Urziceni vor juca la Steaua: Ricardo Gomez, Marius Onofras, Laurentiu Marinescu si Iulian Apostol .
Sambata, 28.08.2010, 00:00